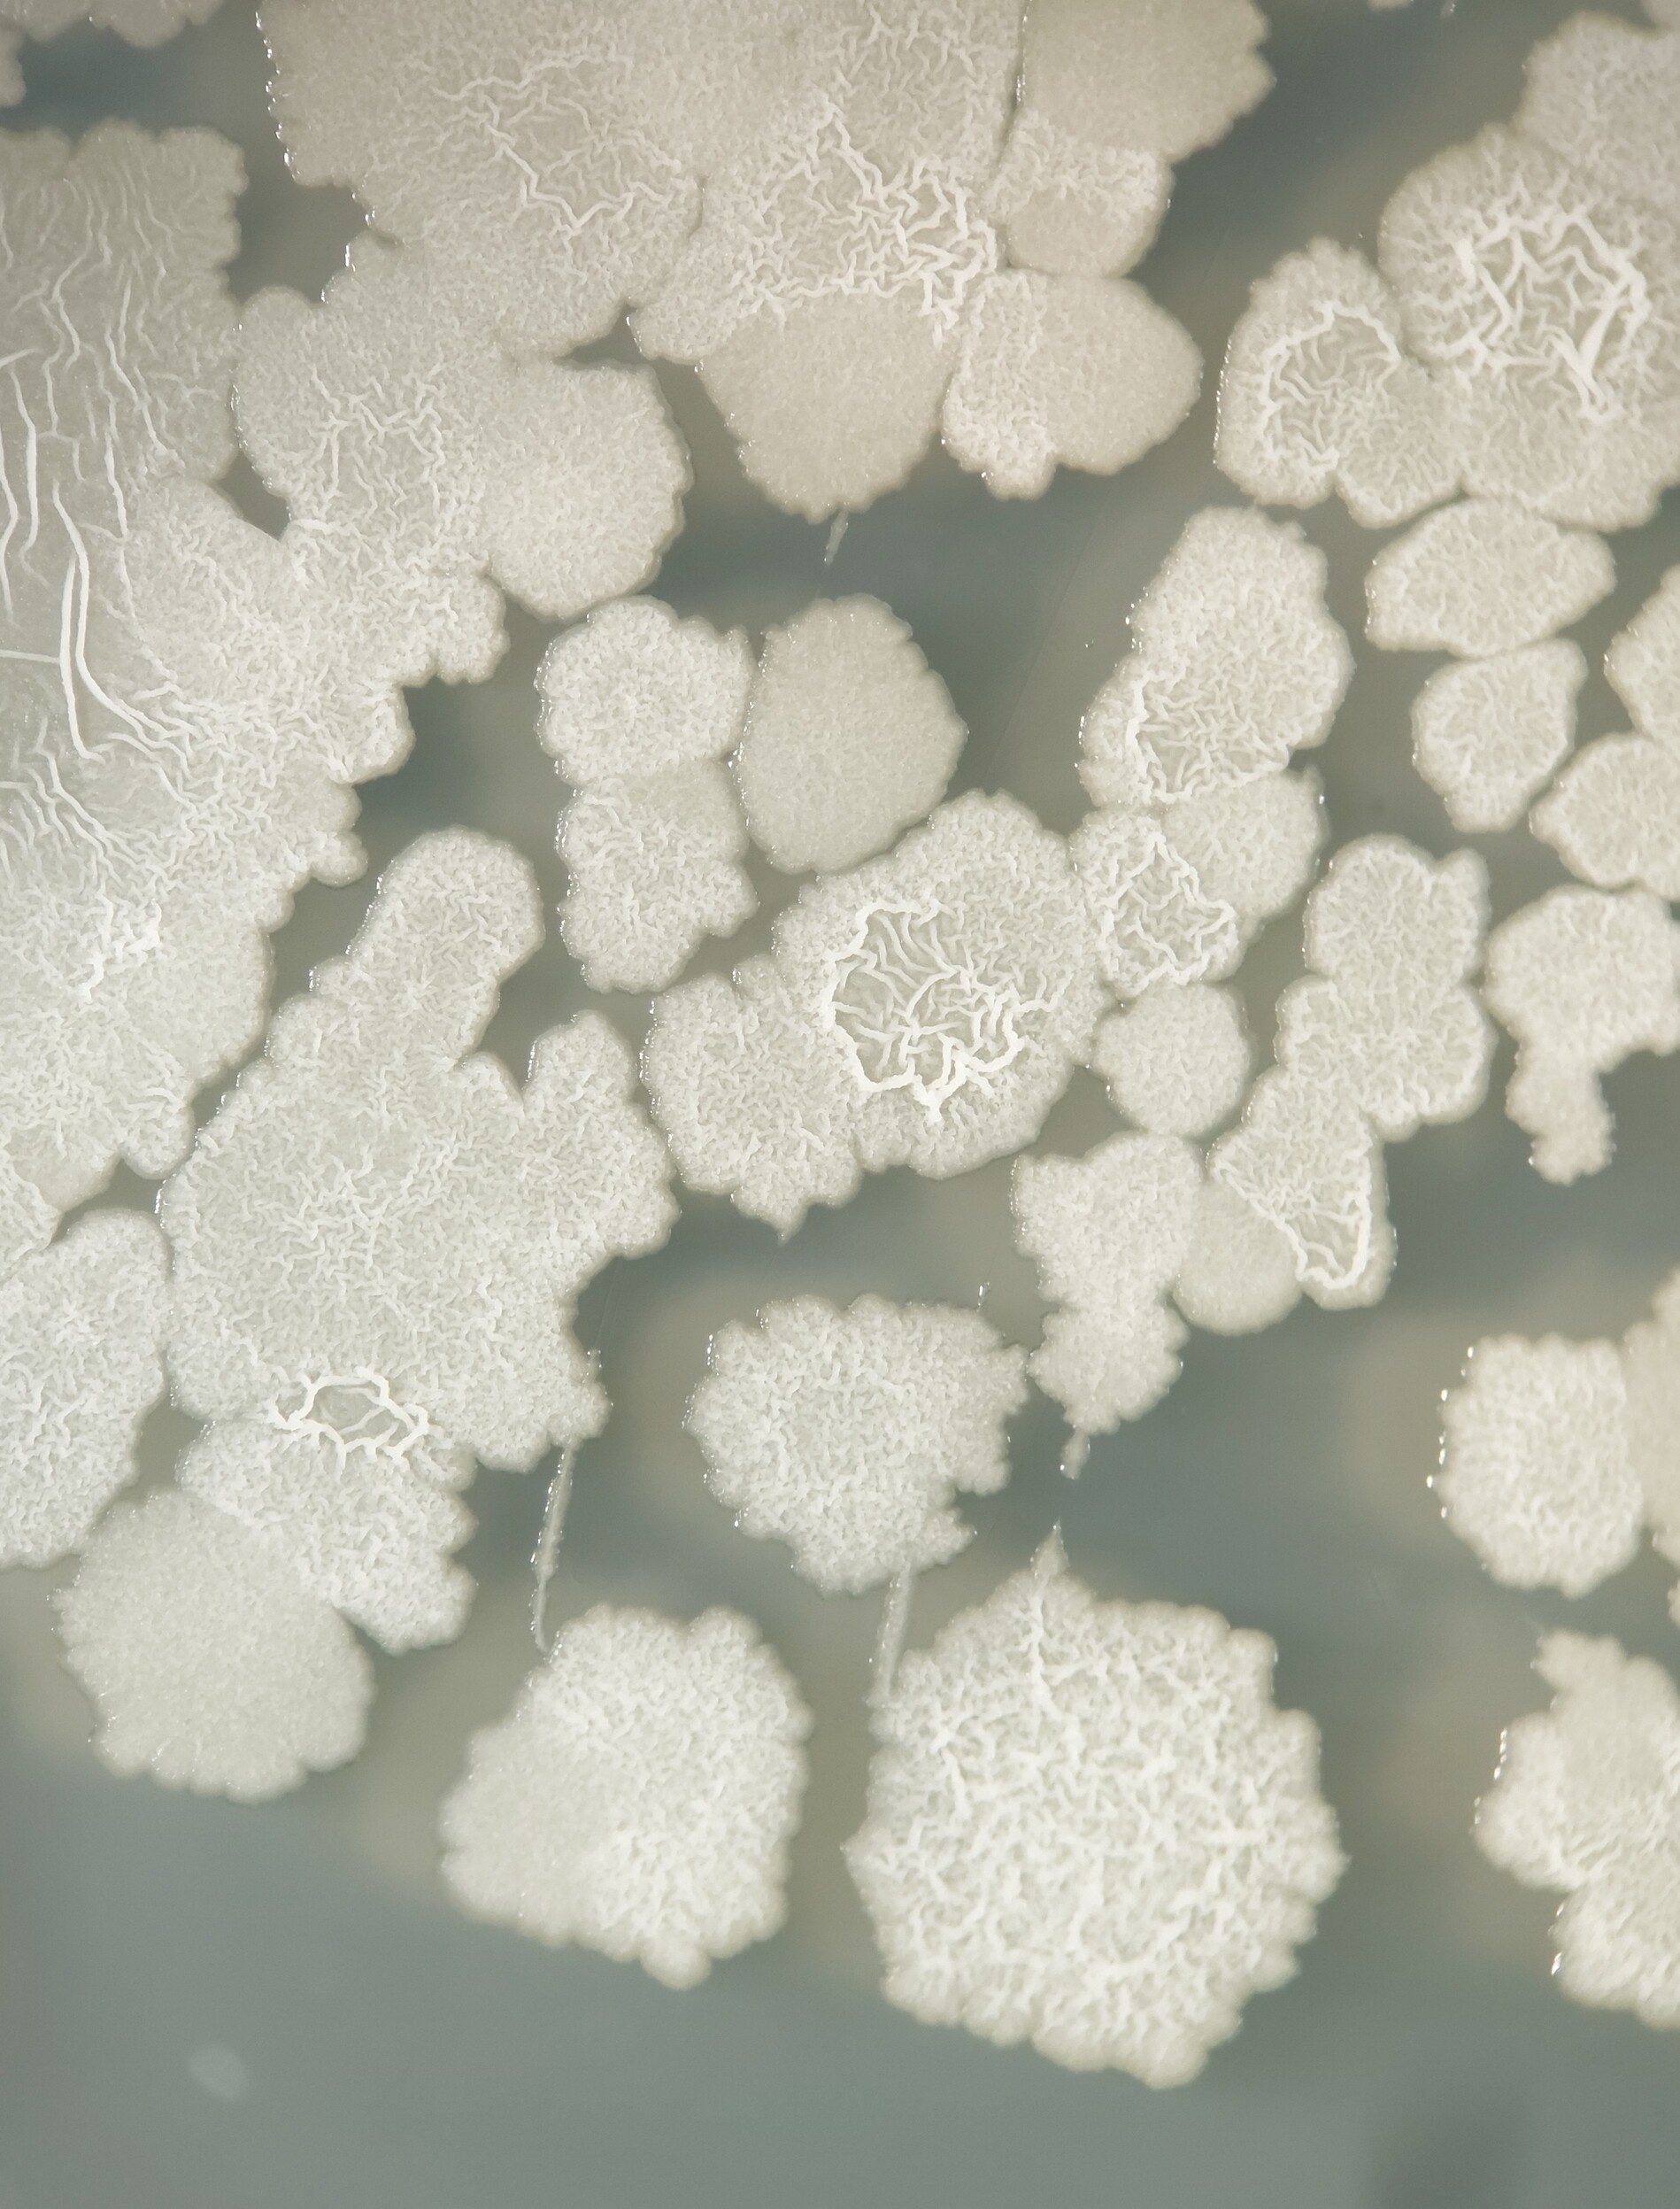

Culturas
Saiba maisConheça nossos projetos
Notícias
Confira nossas últimas publicações
Saber mais
03/11/2025 - Notícias da Imprensa
CONVITTIA reforça a estratégia da Vittia de proximidade e de escuta ativa do campo
Com o conceito “escutamos quem vive o agro todos os dias”, a iniciativa estreita..

27/10/2025 - Notícias da Imprensa
Vittia conquista o Prêmio Líderes do Agronegócio 2025 em Boas Práticas e Compliance
Ribeirão Preto (SP), outubro de 2025 – A Vittia, empresa 100% brasileira e referência..

13/08/2025 - Notícias da Imprensa
Vittia lança podcast para aproximar conhecimento técnico do dia a dia do campo!
“VitExpert ” estreia em formato digital e será apresentado mensalmente com foco em produtividade e..

04/06/2025 - Notícias da Imprensa
Triunfe® é o grande destaque da Vittia na 50ª Expocitros
Novo multissítio concentrado tem composição inédita à base de cobre e enxofre capazes de..

09/05/2025 - Sustentabilidade
O tomate na agricultura brasileira: desafios e oportunidades
O Brasil é um dos maiores produtores de tomate do mundo, com uma produção que ultrapassa..